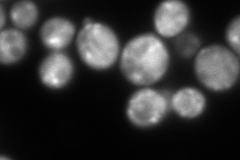
YGR167W
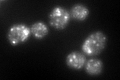
YGR167W

View description
Clathrin light chain, subunit of the major coat protein involved in intracellular protein transport and endocytosis; thought to regulate clathrin function; two Clathrin heavy chains (CHC1) form the clathrin triskelion structural component
Localization:
Intensity:
Fold change:
Significance:
-
C’ GFP library in SD

punctate96.81 -
N' NOP1pr-GFP in SD

punctate207.503 -
N' TEF2pr-mCherry in SD
cytosol,punctate347.931 -
N' NATIVEpr-GFP in SD

punctate,bud38.1686 -
N' TEF2pr-VC and Cyto-VN in SD

cytosol,punctate66.5922 -
C’ GFP library in SD+DTT
punctate107.971.11No -
C’ GFP library in SD+H2O2

punctate85.120.87No -
C’ GFP library in Starvation Media

punctate230.982.38Yes -
C’ GFP library on the background of Pup2-DaMP

punctate -
C’ GFP library on the background of CCT mutant

punctate88.94390.918721No
